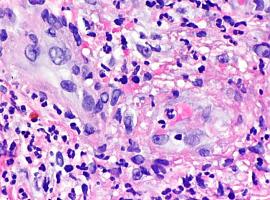

- Hasta el 30 de marzo estarán abiertas las inscripciones en un evento que en la pasada edición reunió a más de 400 personas
Ya está abierto el plazo para que las asociaciones interesadas se inscriban para participar en la VII Feria Avilesina de Asociaciones (FAVA) que se celebrará el sábado 15 de abril en la Plaza de los Hermanos Orbón. Se puede hacer hasta el día 30 de marzo y tiene que hacer a través del formulario que está disponible en la web de Participación Ciudadana www.avilesparticipa
Toda la información, formulario de inscripción en el enlace:
https://avilesparticipa.org/inscribete-y-participa-en-la-feria-avilesina-de-asociaciones-fava-2023/
El tejido asociativo de Avilés viene celebrando esta feria desde 2017. En 2020 y 2021 se realizó de forma diferida a través de Youtube debido a las condiciones impuestas a causa de la crisis sanitaria provocada por el Covid-19.
El pasado año se celebró de forma presencial el sábado 23 de abril, con la implicación de 48 entidades, de las cuales 38 dispusieron de stand informativo y las demás colaborando en la organización y dinamización del espacio.
El lugar de celebración será, como en ediciones anteriores, en la plaza de los Hermanos Orbón. Los puestos informativos de las entidades y asociaciones presentes permanecerán abiertos entre las 11 y las 18 horas, haciendo una pausa para una comida de confraternización del tejido asociativo.
La primera edición, celebrada en el Centro Socio-Cultural de Los Canapés con una participación de 54 entidades, en la segunda fueron 60 las asociaciones avilesinas que visibilizaron su trabajo, en aquella ocasión y por primera vez, en la Plaza Hermanos Orbón.
La tercera edición, con 60 entidades y que se celebró el 27 de abril de 2019, fue la última presencial hasta la fecha, puesto que las condiciones sanitarias ocasionadas por la pandemia del Covid-19 impidieron su edición presencial en los años 2020 y 2021.
En su lugar, el 27 de abril de 2020, fecha en que se conmemoraba la realización de la FAVA del año anterior, se celebró un acto telemático, presidido por la Alcaldesa, en el que participaron, además de la Concejalía, un total de 5 Entidades, que actuaron en representación del total de las mismas.
En 2021, con poco tiempo para organizarse, las entidades prefirieron realizar una edición virtual a través del canal Youtube del Ayuntamiento de Avilés, participando 35 entidades que explicaron los retos y dificultades a los que se enfrentaban en esa etapa tan difícil. El acto estuvo realizado a la manera de una emisión televisiva y tuvo gran alcance con más de 700 visualizaciones. La conexión estuvo presentada por Ana Díaz Tamargo, de la Asociación Rey Pelayo y Esther Larrea, de la asociación Centro Trama Asturias.
En esta edición, las asociaciones han realizado un esfuerzo importante para volver a ilusionar al tejido social y asociativo en unos tiempos en los que aún aprecian las secuelas del confinamiento y el distanciamiento interpersonal de la última época.
Además de un escenario donde mostrar las diferentes habilidades de las asociaciones, se dispondrá de una mesa de actividades en la que también habrá una programación para diferentes talleres interactivos que proponían las entidades.
Esta iniciativa, que surgió en el seno de los 4 Consejos de Participación de Zona en los que se divide la ciudad, está impulsada y coordinada por el Ayuntamiento de Avilés. Tiene entre sus objetivos dar a conocer a toda la ciudadanía la labor que desarrolla cada una de las entidades presentes en el municipio.
Asimismo, pretende ser un punto de encuentro, de intercambio de experiencias entre todas las personas que participan y se implican en cada una de las entidades todos los días del año, y que inciden en ámbitos como el asociativo-vecinal, cultural, deportivo, sociosanitario, o el educativo, entre otros.
El equipo que se encarga de la planificación y organización de la VII Feria Avilesina de Asociaciones está compuesto por 14 personas, integrantes de diversas organizaciones y personas a título individual que representan a los Consejos de Zona. Se distribuyen en tres grupos de trabajo: Intendencia, Difusión, Dinamización, coordinándose entre sí varios meses para que esta feria, compromiso de solidaridad y participación, se haga nuevamente realidad.
La última edición presencial de la FAVA contó con la asistencia de unas 400 personas, en una jornada difícil a causa del mal tiempo, pero que devolvió a las entidades la ilusión de compartir proyectos y mejorar la comunicación interasociativa.
Este año se espera superar el número de asistencia, devolviendo la ilusión a la ciudadanía y a las propias entidades que han pasado por momentos de gran dificultad en esta etapa anterior.